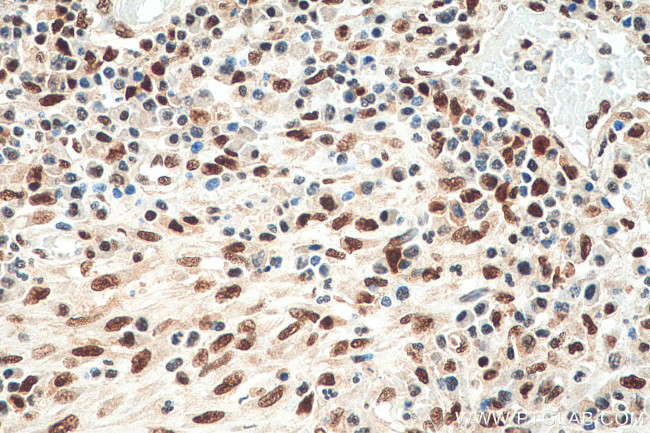
FKBP5 Antibody in Immunohistochemistry (Paraffin) (IHC (P))

Search
Proteintech
FKBP5 Monoclonal Antibody (3B11F3)
{{$productOrderCtrl.translations['antibody.pdp.commerceCard.promotion.promotions']}}
{{$productOrderCtrl.translations['antibody.pdp.commerceCard.promotion.viewpromo']}}
{{$productOrderCtrl.translations['antibody.pdp.commerceCard.promotion.promocode']}}: {{promo.promoCode}} {{promo.promoTitle}} {{promo.promoDescription}}. {{$productOrderCtrl.translations['antibody.pdp.commerceCard.promotion.learnmore']}}
产品信息
67874-1-IG
种属反应
宿主/亚型
分类
类型
克隆号
抗原
偶联物
形式
浓度
规格
纯化类型
保存液
内含物
保存条件
运输条件
产品详细信息
Aliquoting is unnecessary for -20°C storage.
靶标信息
FKBP5 is a member of the immunophilin protein family. This family plays a role in immunoregulation and basic cellular processes involving protein folding and trafficking. FKBP5 is a cis-trans prolyl isomerase that binds to the immunosuppressants FK506 and rapamycin. It is thought to mediate calcineurin inhibition. It also interacts functionally with mature hetero-oligomeric progesterone receptor complexes along with the 90 kDa heat shock protein and P23 protein. The gene that encodes FKBP5 has been found to have multiple polyadenylation sites. Alternative splicing results in multiple transcript variants.
仅用于科研。不用于诊断过程。未经明确授权不得转售。
篇参考文献 (0)
生物信息学
蛋白别名: 51 kDa FK506-binding protein; 51 kDa FKBP; 54 kDa progesterone receptor-associated immunophilin; Androgen-regulated protein 6; EC 5.2.1.8; FF1 antigen; FK506 binding protein 5; FK506-binding protein 5; FKBP-5; FKBP-51; FKBP54; HSP90-binding immunophilin; p54; Peptidyl-prolyl cis-trans isomerase FKBP5; peptidylprolyl cis-trans isomerase; peptidylprolyl isomerase; PPIase FKBP5; Rotamase; T-cell FK506-binding protein; unnamed protein product
基因别名: AIG6; D17Ertd592e; Dit1; FKBP-5; FKBP5; FKBP51; FKBP54; P54; PPIase; Ptg-10
UniProt ID: (Human) Q13451, (Mouse) Q64378, (Rat) Q5U2T9
Entrez Gene ID: (Human) 2289, (Mouse) 14229, (Rat) 361810